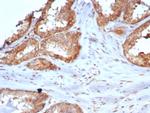
CARM1 Antibody in Immunohistochemistry (Paraffin) (IHC (P))

Search
NeoBiotechnologies
CARM1 Monoclonal Antibody (CARM1/7426)
{{$productOrderCtrl.translations['antibody.pdp.commerceCard.promotion.promotions']}}
{{$productOrderCtrl.translations['antibody.pdp.commerceCard.promotion.viewpromo']}}
{{$productOrderCtrl.translations['antibody.pdp.commerceCard.promotion.promocode']}}: {{promo.promoCode}} {{promo.promoTitle}} {{promo.promoDescription}}. {{$productOrderCtrl.translations['antibody.pdp.commerceCard.promotion.learnmore']}}
产品信息
10498-MSM3-P0
种属反应
宿主/亚型
分类
类型
克隆号
抗原
偶联物
形式
浓度
规格
纯化类型
保存液
内含物
保存条件
运输条件
靶标信息
Protein arginine N-methyltransferases, such as CARM1, catalyze the transfer of a methyl group from S-adenosyl-L-methionine to the side chain nitrogens of arginine residues within proteins to form methylated arginine derivatives and S-adenosyl-L-homocysteine. Protein arginine methylation has been implicated in DNA packaging, transcription regulation, signal transduction, mRNA stability, metabolism of nascent pre-RNA, and transcriptional activation. Tissue specificity: Overexpressed in prostate adenocarcinomas and high-grade prostatic intraepithelial neoplasia.
仅用于科研。不用于诊断过程。未经明确授权不得转售。
篇参考文献 (0)
生物信息学
蛋白别名: Coactivator-associated arginine methyltransferase 1; Histone-arginine methyltransferase CARM1; Protein arginine N-methyltransferase 4
基因别名: CARM1; PRMT4
UniProt ID: (Human) Q86X55
Entrez Gene ID: (Human) 10498